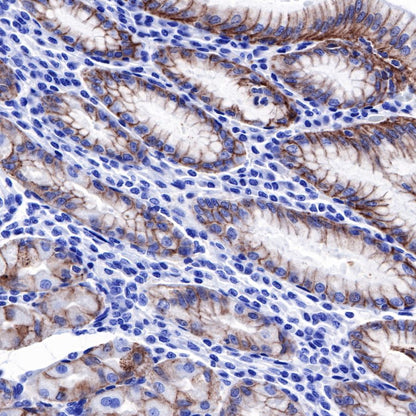

Immunohistochemistry protocol:
- Cut and mount sections on slides coated with a suitable tissue adhesive.
- De-paraffinize sections in xylene or xylene substitutes.
- Re-hydrate through graded alcohols.
- Wash slides in distilled H2O.
- Perform antigen retrieval as required.
- Wash slides in distilled H2O.
- Quench endogenous peroxidase using Hydrogen Peroxide Block for 5-10 minutes.
- Wash in wash buffer for 3 x 3 minutes.
- Incubate with optimally diluted primary antibody.
- Wash in wash buffer for 3 x 3 minutes.
- Incubate with ready to use Goat anti-Rabbit&Mouse HRP Conjugate for 15-30 minutes.
- Wash in wash buffer for 3 x 3 minutes.
- Add DAB working solution (DAB substrate diluted with DAB dilution buffer) until color development finish.
- Rinse slides in water.
- Add 100ul Haematoxylin and incubate for 3 minutes, then rinse slides in water.
- Clear and mount sections